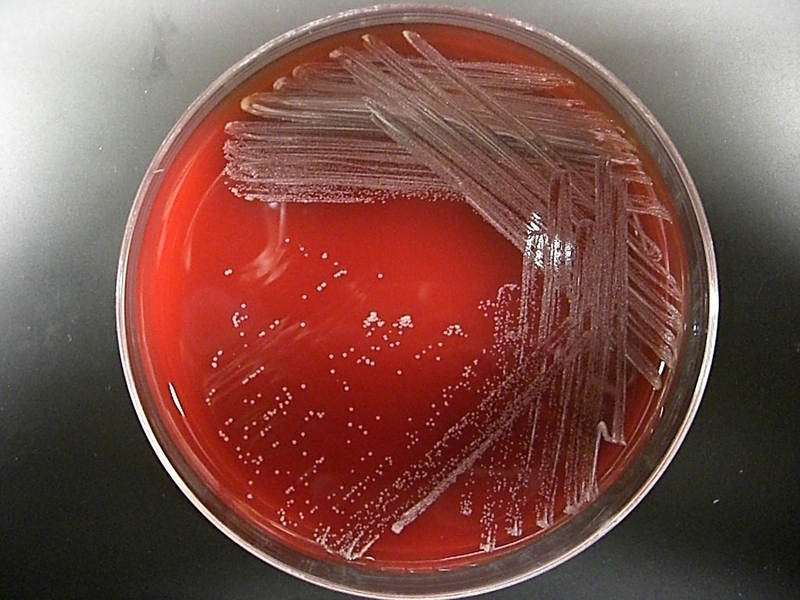
Lịch tiêm chủng bạch hầu ho gà uốn ván - Những điều bạn cần biết 2

Từng làm ở Viện ISDS, nhiều năm cộng tác với CDC Thái Nguyên triển khai dự án phòng chống HIV/AIDS, 2 năm cộng tác với WHO.
21/06/2023
Mặc định
Lớn hơn
Bạch hầu, ho gà và uốn ván là những căn bệnh vô cùng nguy hiễm. Bài viết thông tin về lịch tiêm chủng bạch hầu ho gà uốn ván và lý do tại sao nên tiêm phòng những bệnh này.
Nhờ vào những tiến bộ khoa học, con người có thể phòng chống được hầu hết các loại bệnh nguy hiểm hiện nay chỉ qua việc tiêm vắc xin phòng bệnh. Việc tiêm chủng phòng bệnh cho trẻ em là vô cùng quan trọng, không chỉ bảo vệ sức khỏe của chính đứa bé mà còn giúp ngăn ngừa dịch bệnh lây lan trong cộng đồng.
Có rất nhiều căn bệnh lây nhiễm cho con người và có thể ảnh hưởng đến sức khỏe hay thậm chí là tính mạng của bệnh nhân. Trong đó, uốn ván, bạch hầu và ho gà là ba căn bệnh nguy hiểm cần được tiêm phòng. Sau đây là những thông tin về 3 căn bệnh này và lịch tiêm chủng bạch hầu ho gà uốn ván.

Lịch tiêm chủng bạch hầu ho gà uốn ván và những điều bạn cần biết.
Bạch hầu là bệnh do độc tố của trực khuẩn Corynebacterium Diphtheria (trực khuẩn bạch hầu) gây nên. Độc tố do trực khuẩn bạch hầu tiết ra gây tổn thương tại nhiều cơ quan và tổ chức của cơ thể.
Hình ảnh trực khuẩn Corynebacterium Diphtheria gây bệnh bạch hầu.
Bệnh bạch hầu có thể lan truyền từ người sang người trực tiếp qua không khí và gián tiếp qua những vật dụng người bệnh tiếp xúc. Bệnh nhân bạch hầu ủ bệnh trong 2 tuần rồi bắt đầu phát bệnh và lây nhiễm cho người khác.
Những dấu hiệu của bệnh bạch hầu là sốt nhẹ, đau họng, ho, khàn tiếng. Nhũng giả mạc màu trắng ngà, xám hoặc đen sẽ xuất hiện ở mặt sau hoặc hai bên họng dai dính và rất dễ chảy máu. Đây là dấu hiệu đặc trưng nhất của bệnh bạch hầu.
Trong vòng 6 - 8 ngày từ khi phát bệnh, bệnh nhân có thể tự khỏi hoặc bệnh sẽ trở nặng hơn. Bệnh nhân bạch hầu nặng có dấu hiệu sưng cổ, khó thở, khàn tiếng, nhịp tim rối loạn hay thậm chí là liệt.
Nếu không được phát hiện kịp thời, bệnh nhân bạch hầu có thể bị viêm cơ tim và tử vong đột ngột do trụy tim. Một số người không bị trụy tim thì chứng viêm cơ tim do bạch hầu để lại di chứng suy tim hoặc bệnh tim mãn.
Bệnh bạch hầu vô cùng nguy hiểm, việc tuân thủ lịch tiêm chủng bạch hầu ho gà uốn ván giúp bảo vệ tương lai của con trẻ.
Ho gà là tên căn bệnh cấp tính do vi khuẩn Bordetella pertusis (vi khuẩn ho gà) gây ra. Căn bệnh nhiễm khuẩn đường hô hấp này có thể gây nên nhiều biến chứng nguy hiểm, thậm chí có thể dẫn đến tử vọng. Bệnh có tốc độ lây lan nhanh và có thể phát triển thành dịch ho gà.
Sở dĩ bệnh được gọi là bệnh ho gà là vì trẻ nhiễm bệnh thường ho có tiếng rít như tiếng gà trống khi gần hết tiếng gáy. Khi mắc bệnh, vi khuẩn ho gà bám vào nhung mao đường hô hấp và tiết ra độc tố khiến nhung mao tổn thương và hoại tử. Những tế bào hoại tiết ra chất histamin gây kích thích đường hô hấp khiến bệnh nhân ho dữ dội và liên tục. Thậm chí nếu điều trị bệnh khỉ hoàn toàn thì cơn ho cũng có thể kéo dài một khoảng thời gian dài do dư lượng histamin trong máu.

Cơn ho có thể kéo dài dù đã điều trị bệnh ho gà.
Khi vi khuẩn ho gà xâm nhập cơ thể thì sau hai tuần bệnh nhân sẽ lên cơn sốt, bắt đầu hắt hơi và thở ra vi khuẩn. Người bình thường hít phải không khí chứa vi khuẩn ho gà mà chưa có kháng thể thì rất dễ bị nhiễm bệnh. Ho gà rất dễ lây lan trong cộng đồng nên cha mẹ cần tuân thủ lịch tiêm chủng bạch hầu ho gà uốn ván để bảo vệ sức khỏe con trẻ và cả cộng đồng.
Uốn ván là bệnh nhiễm khuẩn cấp có tỷ lệ tử vong rất cao (có thể lên đến 90% đối với trẻ em không được tiêm chủng). Bệnh do độc tố tetanospasmin do trực khuẩn Clostridium tetan sinh ra. Bệnh này đã được biết đến từ lâu nhưng do sự chủ quan của người lớn mà nhiều cái chết đáng tiếc vẫn xảy ra do trẻ không được tiêm phòng theo lịch tiêm chủng bạch hầu ho gà uốn ván.

Xác suất tử vong của trẻ sơ sinh mắc bệnh uốn ván có thể lên đến 90%.
Bệnh uốn ván có thời gian ủ bệnh dao động từ 7 ngày đến vài tuần lễ, thời gian ủ bệnh càng ngắn thì bệnh càng nặng. Biểu hiện đặc trưng của bệnh uốn ván là cơ căng cứng, miệng không mở to được. Tiếp theo là các cơn co giật sẽ xuất hiện. Cơn co cứng lan từ cơ mặt, cổ, lưng đến tay, chân và bụng. Trẻ mắc bệnh uốn ván sẽ có tư tế đặc trưng là lưng bị uốn cong, cổ ngả về sau, tay khép vào thân, chân duỗi thẳng, cơn co cứng kéo dài trong khoảng 15 - 30 ngày.
Bệnh nhân uốn ván có thể bị rối loạn nhịp tim khiến huyết áp tăng thất thường, nhịp tim tăng cao, sốt cao, ra nhiều mồ hôi. Đôi khi bệnh có thể bị hạ huyết áp gây chậm nhịp tim, có trường hợp tim ngừng đột ngột gây đột tử.
Bạch hầu, ho gà và uốn ván là những căn bệnh nguy hiểm với con người và cả xã hội. Để bảo vệ sức khỏe cho bé, cha mẹ cần tuân thủ lịch tiêm chủng bạch hầu ho gà uốn ván.
Theo lịch tiêm chủng mở rộng của Bộ Y tế, trẻ từ lúc mới sinh cho đến khi 1 tuổi sẽ phải trải qua đợt tiêm chủng lớn nhất trong đời với hàng chục loại vắc xin khác nhau. Hệ miễn dịch của trẻ sơ sinh còn yếu và đặc biệt là trẻ không được bú mẹ hoặc trẻ đã cai sữa. Do đó, cần tiêm cho bé sớm nhất có thể để tạo kháng thể cần thiết giúp bảo vệ ơ thể khỏi những loại bệnh nguy hiểm.
Dưới đây là lịch tiêm chủng bạch hầu ho gà uốn ván mới nhất:
Giai đoạn từ 1 - 5 tuổi, đa phần các bé chỉ tiêm hoặc uống vắc xin nhắc lại. Một số loại vắc xin chỉ dành cho những bé sống tại khu vực có nguy cơ mắc bệnh cao.
Qua bài viết, hy vọng bạn đã biết lịch tiêm chủng bạch hầu ho gà uốn ván và hiểu tại sao việc tiêm chủng lại vô cùng quan trọng.
Uyên
Dược sĩ Đại học Nguyễn Tuấn Trịnh
Từng làm ở Viện ISDS, nhiều năm cộng tác với CDC Thái Nguyên triển khai dự án phòng chống HIV/AIDS, 2 năm cộng tác với WHO.